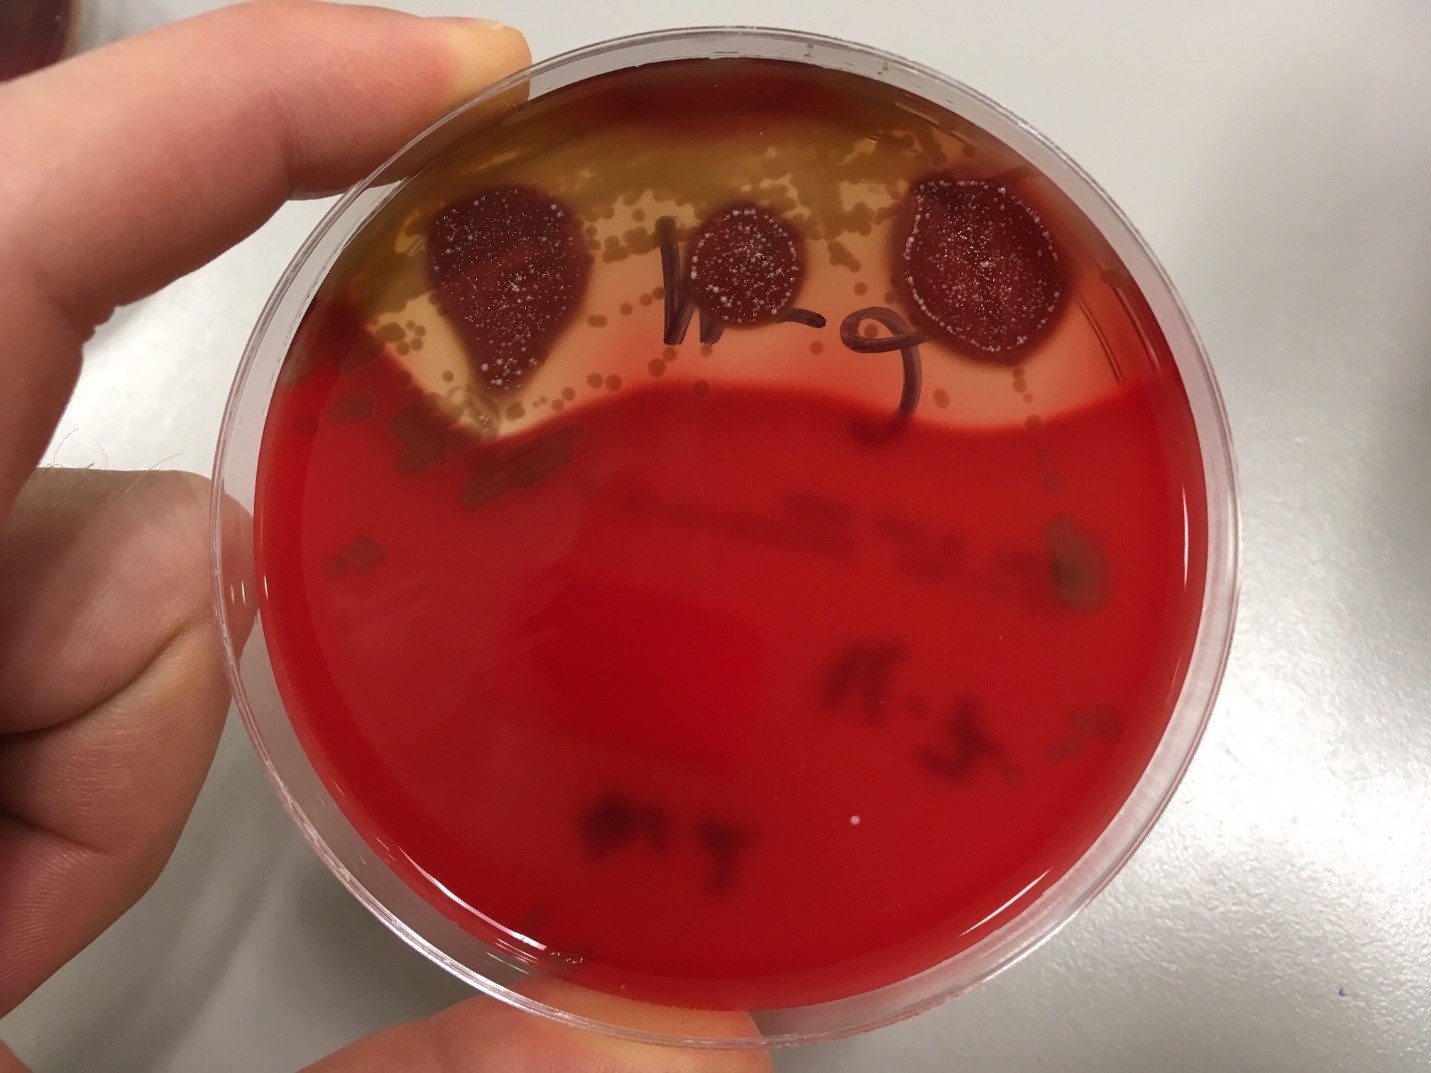

Case History
The patient is a 21 year old male with a history of developmental delay and chronic kidney disease secondary to posterior urethral valves, status post kidney transplant at age 14, who presents for a routine office visit with his pediatric nephrologist. In the past year, he has had chronic antibody-mediated transplant rejection despite immunosuppression. In addition, he drinks 1-1.5 gallons of water daily, self-catheterizes every three hours, and has an indwelling Foley at night. During the office visit, he denies any urinary symptoms, including dysuria, hematuria, cloudy urine, reduced output, or fever. However, given his significant risk factors for urinary tract infection, his provider orders a urinalysis and urine culture.
Laboratory Identification
The urine was noted to be cloudy, was positive for nitrites and leukocyte esterase, and had 11-50 white blood cells per high-powered field.
Urine culture demonstrated the growth of two organisms, one of which was identified to be greater than 100,000 CFU of Proteus miribalis, and the second of which grew 10,000-100,000 CFU, was isolated, and is shown below:

Mass spectrometry by MALDI-TOF confirmed that this second organism is Streptococcus pneumoniae, a bile-soluble gram positive diplococci.
Discussion
S pneumoniae is implicated in a number of diseases, but it is an uncommon pathogen in the urine. Several case-series and case reports have been published demonstrating a predilection of pathogenic urinary S pneumoniae for pediatric patients with urinary tract abnormalities. In one series, 26 urine cultures from 18 patients were identified as growing S pneumoniae, with CFU counts ranging from 100 to 100,000. Sixteen of the 26 cultures grew only S pneumoniae. Of the 18 patients, only six were adults, eight had had a kidney transplant, and four others had chronic problems with their kidneys (1). In another series of three pediatric cases, one patient had congenital bilateral duplication of the renal collecting system, one had a “congenital imperforate anus (high type 1A) with a rectovesical fistula and grade 4 bilateral vesicoureteral reflux,” and the third had bilateral renal dysplasia (2). Neither case series was able to identify a specific serotype of S pneumoniae responsible for these infections.
As discussed by Choi et al, the altered flow dynamics of the abnormal urinary systems in these patients may be compromising normal host immune clearance mechanisms, thereby increasing the susceptibility to infection (2, 3). However, it is unclear why S pneumoniae infections have a predilection for congenital urinary tract abnormalities, as opposed to all urinary tract abnormalities. Choi et al postulate that some of the gene polymorphisms known to predispose individuals to UTI or pneumococcal infections could be genetically linked to genes responsible for urinary tract abnormalities, thus increasing the probability that an individual with a congenital urinary tract abnormality would have an S pneumoniae urinary tract infection (2,4).
Given the patient’s history and risk factors, the presence of S pneumoniae in his urine was found to be significant. Treatment of both organisms and appropriate follow-up was recommended.
References
- Burckhardt, Irene, Jessica Panitz, Mark van der Linden, and Stefan Zimmermann. “Streptococcus pneumoniae as an agent of urinary tract infections – a laboratory experience from 2010 to 2014 and further characterization of strains.” Diagnostic Microbiology and Infectious Disease. 2016; 86: 97-101.
- Choi, Rihwa, Youngeun Ma, Kyung Sun Park, Nam Yong Lee, Hee Yeon Cho, and Yae-Jean Kim. “Streptococcus Pneumoniae as a uropathogen in children with urinary tract abnormalities.” The Pediatric Infectious Disease Journal. 2013; 32(12): 1386-1388.
- Bogaert, D, R de Groot, PWM Hermans. “Streptococcus pneumoniae colonization: the key to pneumococcal disease.” The Lancet Infectious Diseases. 2004; 4(3): 144-154.
- Yuan, Fang Fang, Katherine Marks, Melanie Wong, Sarah Watson, Ellen de Leon, Peter Bruce McIntyre, John Stephen Sullivan. “Clinical relevance of TLR2, TLR4, CD14, and Fc gamma RIIA gene polymorphisms in Streptococcus pneumoniae infection.” Immunology and Cell Biology. 2008; 86(3): 268-270.
-Fritz Eyerer, MD is a first year Anatomic and Clinical Pathology Resident at the University of Vermont Medical Center.

-Christi Wojewoda, MD, is the Director of Clinical Microbiology at the University of Vermont Medical Center and an Associate Professor at the University of Vermont.
Hi Christi, just wondering did you guys use your own library to identify the strep pneumoniae by maldi tof-ms cos I know there’s a differential issue between pneumococcal and SMG when using the maldi tif-ms. Cheers, Michael
Hi Michael,
My apologies for not replying sooner! We used the Vitek MS database (most recent update) and confirm with bile solubility.
Happy Holidays,
Christi
Many thanks for your reply. Wish you guys have great Christmas and new year holidays too.